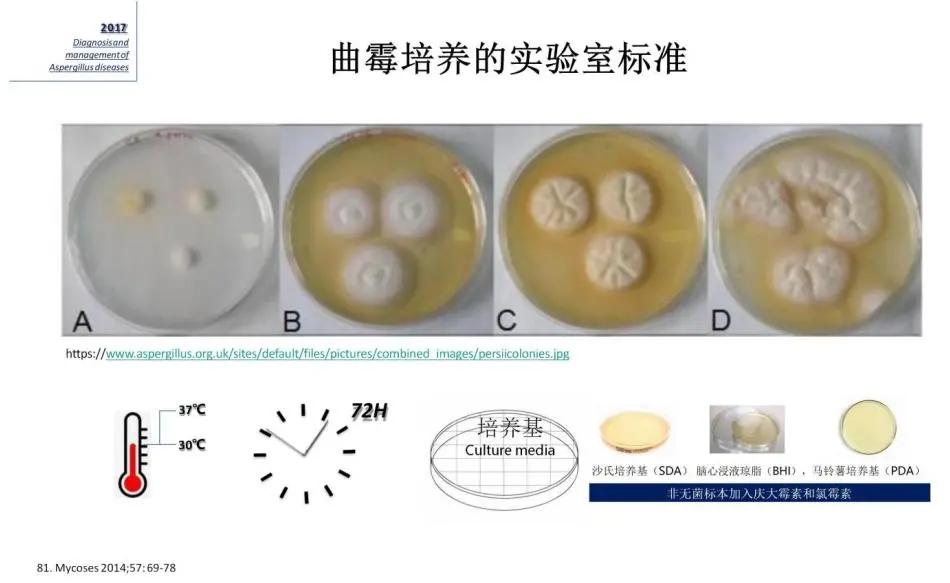
病原微生物检测是细菌培养吗,临床微生物检验与感染

今天是关于真菌的讨论,主要是从呼吸道分泌物真菌培养阳性的结果来探讨它的意义,究竟如何判定它是感染?是污染?还是定植?这个话题其实有点难度。
当一张临床标本病原微生物培养检验报告单(包括mNGS检测)在手,尤其真菌检测为阳性时,我们到底该如何看待这个「阳性」?

如同我们常说的「感染性疾病是一个永恒三角」,而真菌感染是一个更加困难的永恒三角。

在所有的真菌感染诊治原则里,从2008年到现在,一直都是延续地应用的「疑诊」、「可能诊断」和「确诊」,中文叫做拟诊、临床诊断和确诊,其中要拿到临床诊断或者是确诊的依据,都要有微生物学依据。因此,真菌病原学检查是临床诊断和确诊的「金标准」,是不可缺少的。

这些年来,真菌病的微生物诊断方法在不断进展。除了常规的实验室检查如真菌的涂片镜检和培养之外,生物标志物检测,如真菌G、GM抗原检测试验,尤其是近两年的分子生物学,包括PCR、mNGS都有了明显的发展,确实也给临床提供了非常大的帮助。但是,常规实验室检查里真菌的涂片镜检和培养,所有的专家共识都认为它还是真菌实验室检查的基石,虽然它的敏感性偏低了一些。

在临床中,感染问题是众多临床医师每天都要面对的问题, 当一张临床标本病原微生物培养检验报告单(包括mNGS检测)在手,尤其是真菌检测阳性时,你该如何鉴别它的准确性?它的参考价值有多大?是定植还是感染?该治疗还是观察? 我们每天都要问这个问题。就如同我们每天都行走在一条「分岔路」,到底该往哪里走?即使我们的技术已经发展到现在的程度,仍然是非常困难的,但它又非常有意义。
意义何在呢? 因为如果将定植、污染判断为感染,就会导致临床的过度治疗,会增加不良反应的发生率,诱导耐药性的产生;但如果将感染判断为定植、污染,又会延误临床治疗,会增加患者的病死率。因此区分它们尤为重要。

想要区分它们,无菌部位的培养结果比较容易判断,但在开放系统,包括如泌尿系统、消化道和腹腔等等,就会比较困难,尤其是呼吸道。因为肺部感染特别多见,而呼吸道的标本又容易受到口咽部、鼻咽部这些部位正常菌群的影响。我们培养出来的病原体究竟是定植还是感染?有时真的难以判断,即使采用肺泡灌洗,仍然不能完全解决这个问题。细菌已经这么难,如果是培养真菌,那更是难上加难。

举个例子: 就用念珠菌来说明。我们知道在呼吸道标本里,肺泡灌洗已经是非常不容易获得了,但对于念珠菌而言,即使肺泡灌洗液检测到了,它的意义仍然不大。我们看看国外的指南。

具体看2016年对比2009年IDSA念珠菌病治疗指南对这一问题的描述有何变化? 2009年时,IDSA念珠菌病的指南当提到呼吸道分泌物的时候,说:呼吸道分泌物念珠菌阳性很少代表感染,直接告诉我们, A-III级的循证证据是不应进行抗真菌治疗。 到2016年稍微有一点变化,说: 呼吸道分泌物念珠菌阳性通常表示定值,很少需要抗真菌治疗。 这个结论没有像2009年时说得那么绝对,「很少需要」说明还有可能需要,但我们要注意的是,为什么2009年时说得那么绝对?我们需要思考,到底应该如何看待呼吸道分泌物培养阳性的这个结果?
如何鉴别「阳性」结果的准确性?其参考价值多大?是污染、定植还是感染?该治疗还是继续观察?……首先考验临床医生的基本功
如何鉴别「阳性」结果的准确性?其参考价值多大?是污染、定植还是感染?该治疗还是继续观察?首先要考验的是临床医生的基本功,看看临床医生应该怎么做。
我们说一个标本要拿去做培养,首先这个标本要采集得正确,运送是规范的,问题在于,我们临床上送的那么多标本,如:血标本、呼吸道标本、中段尿标本、腹腔分泌物标本、伤口分泌物标本、提供给实验室完整的标本信息等等,尤其是呼吸道标本,我最想问的是,你送的那个真的是痰吗?这真得好好打一个问号。所以, 正确规范地采集和运送标本,是一个临床医师的基本功。
一个优秀的临床医生应该知道,如果想了解呼吸道标本,就应该首先清楚何为最佳标本? 最佳标本是指具有很高诊断价值的标本。 比如,组织和无菌体液(血、骨髓、脑脊液、关节液、胸腹腔穿刺液)标本,这些标本都具有很高的诊断价值。那么呼吸道标本呢? 现有的证据告诉我们,对于呼吸道感染来说,最好的一定是BALF(呼吸道标本:BALF>抽吸分泌物>诱导痰>深部痰) 。可见,除了穿刺有效的检查,其次是经气道的分泌物,然后是诱导痰,最差的是深部痰,更别提是那种随口吐出来的那一点点痰。大家都应该认识到,痰的临床意义真的很有限,但反过来看,痰又是临床送检率最高的标本。 中国百分之六七十都是送的痰标本 ,因此痰标本的可靠性关键是在临床,临床医生必须知道正确的留取痰标本的方法。然而简单归纳一下国内目前的现状:有适应证也不做(意识很差),即使做了套数不足、容量不够、保存与运送不当、实验室没有及时上机等等。
怎样才算是一份合格的痰标本呢? 讲起来大家好像都知道,特别是呼吸科医生,说正确的痰标本不就是典型的这句话吗? 「明晨留痰,送痰培养,从深部咳出来的痰」 。好,我们现在就来分析这一句话。是的,清晨的痰,隔了一夜含菌量是高的,也是最佳的采集时间。可是你知道吗?第一,你今天下了医嘱明晨留痰送检,可今天就把抗菌药物用上去了,确实重症病人很难等到明天再用抗菌药物,但抗菌药物用上了还能做得准确吗?第二,我曾经专门跟着科里的医生,就想看看他们下医嘱后到底标本是怎么交代给病人的,我就发现办公室护士接受医嘱后,多半是这样的情况,XXX 「给某床送一个痰盒子,明天留痰」 。就这么一句话。我又跟着护士去看,护士就把痰盒子往那个病人旁边一放,说, 「明天早上吐口痰」 。至于明天早上吐的是啥?根本就不知道。因此,所谓合格痰我们经常是拿不到的,更别说要去判断什么样的痰是合格的,根本就说不清楚。这就是我们目前临床的现状。
现在再来回答这个问题,怎样才算是一份合格的痰标本? 1、咳痰标本的采集方法:(1)医师或护士直视下采集标本,如有必要,可用吸痰器采集;(2)病人先用无菌生理盐水漱口,去除表面的菌群;(3)教育病人深咳,收集从下呼吸道咳出的痰液。2、时间要求:(1)清晨的痰含菌量最多,是最佳采集时间;(2)在抗菌药物应用之前采集痰标本;(3)标本采集后 1~2h 内必须立即进行实验室处理;(4)如果无痰,可用 3%~5%NaCl 5ml 雾吸约5min导痰,也可用物理疗法、体位引流、鼻导管抽吸等法取痰;(5)不建议 24h 内多次采集,除非痰液外观性状出现改变。3、一份合格痰标本应该是痰涂片镜检每低倍视野 <10 个鳞状上皮细胞,>25 个多核白细胞。
想找什么样的病原体,与取什么样的标本以及标本的数量等等都密切相关……临床医生如何下医嘱都会直接影响到检出结果

如何选取恰当的样本类型? 我们要知道,对不同的病原体,即使都是呼吸道标本,它的要求也是不一样的。比如:对于所有的病原学来说,痰和BALF都是最好的。但对于病毒而言,还有咽拭子是好的,但反过来你如果用咽拭子去做细菌、做非典型病原体,它是不好的。所以,对于你想找什么样的病原体,与你取什么样的标本,以及标本的数量等等,都是密切相关的。

因此我们看到2017年的欧洲指南里说,对于真菌感染而言气道标本是这样推荐的。首先可以看到,如果选送得比较好,痰标本是A-III级的证据,它也是我们真菌实验室检查最基本的检查。包括BALF也是最基本的检查,特别是曲霉。曲霉分离率的高低是依赖于BALF里面的菌含量,标本离心后再进行培养和镜检才能提高检出率。
同时临床医生还应该要注意的是,要提醒检验科的医师。 为什么?如果我们不去提醒这个病人在临床上高度怀疑真菌感染,只是按照常规申请痰培养,很可能检验科的医师将标本培养3天,没有菌生长就扔掉了。但如果我们交代一句,这个病人我们高度怀疑真菌感染,那么实验室就可能把培养的时间延长到7-10天,就会增加检出率。所以, 临床医生如何下医嘱,都会影响到检出结果。 尤其是如果你高度怀疑为真菌感染,实验室可能就会用常规培养基之外的、特殊的、对真菌培养有特别效果的培养基,比如说沙保培养基(SDA)、脑心浸液琼脂(BHI)、马铃薯培养基(PDA)等,甚至有可能会加一些抗菌药物如庆大霉素和氯霉素来抑制细菌生长,从而更有利于真菌的生长。

从上呼吸道标本类型及适应证我们可以看到,不同的标本,不同的感染,取的标本是不一样的。如果是上呼吸道,真菌多半是念珠菌,所以主要取的标本就是口腔的黏膜拭子、舌拭子或口咽拭子。

但如果是下呼吸道真菌的感染,不论是社区获得性肺炎、院内获得肺炎、胸腔感染(肺脓肿、脓胸)、免疫低下患者的肺炎、CF患者肺炎,可以看到,下呼吸道标本中,痰和支气管镜标本是最为重要的。它与上呼吸道标本完全不一样。

对于医院获得性肺炎,如果想培养出曲霉,同样可以看到,不论是真菌涂片还是培养,最好的标本一定是支气管的抽吸物,是肺泡灌洗液,是保护性毛刷,甚至连抗原(如GM试验)的检测,肺泡灌洗液都是最好的标本。
为什么说在呼吸道标本里肺泡灌洗液是最好的呢? 因为它的阳性率最高,合格率容易最高。因为做肺泡灌洗是不需要患者配合就能取出合格的标本来,又能够尽量地避免上呼吸道定植菌的污染,从而减少对培养结果判断的干扰。所以如果我们有可能,就应该尽量去取肺泡灌洗液来送检。因此对肺泡灌洗液标本的优点作一个小结:
1、BALF标本培养的阳性率高,合格率高;
2、BALF的采集不需要患者的配合;
3、BALF能避免上呼吸道定植菌的污染,减少对培养结果判断的干扰。

这是危重患者中的下呼吸道标本获取:灌洗和刷检图示。中华急诊医学杂志上发布的《支气管镜在急危重症临床应用的专家共识》,描述了纤支镜在重症患者病原学诊断中的应用价值:经纤支镜保护性毛刷的刷检(图A);中华医学会呼吸病学分会呼吸危重症学组 2020 年发布《 ICU 患者支气管肺泡灌洗液采集、送检、检测及结果解读规范》,明确了支气管肺泡灌洗操作的规范和质量控制(图B-C)。这些共识就是告诉我们,要正确地使用支气管镜,正确的进行肺泡灌洗,规范地采集标本,从而为实验室正确地进行真菌镜检和培养打下基础。这是每一个临床医师应该掌握的基本功。
参考文献
[1] J Peter Donnelly, et al. Clin Infect Dis. 2020 Sep 12;71(6):1367-1376.
[2] 中国医师协会血液科医师分会,中国侵袭性真菌病工作组.血液病/恶性肿瘤患者侵袭性真菌病的诊断标准与治疗原则(第六次修订版).中华内科杂志.2020,59(10):754-763
[3] Journal of Computer Assisted Tomography 26(2):159–173 Eur Respir Rev 2011; 20: 121,
156–174
[4] Clinical practice guideline for the management of invasive diseases caused by Aspergillus:2018 Update by the GEMICOMED-SEIMC/REIPI
[5] 81. Mycoses 2014;57: 69-78
[6] American Thoracic Society, Infectious Diseases Society of America. Guidelines on the Management of Community-Acquired Pneumonia in Adults, 2007:44 (Suppl 2)
[7] 支气管镜在急危重症临床应用专家共识组.中华急诊医学杂志, 2016,25(5) : 568-572
[8] 中华医学会呼吸病学分会呼吸危重症医学学组.中华结核和呼吸杂志, 2020,43(09) : 744-756.
本文由《呼吸界》编辑 冬雪凝 整理,感谢施毅教授的审阅修改!
本文完
*今条头日**排版:刘旋